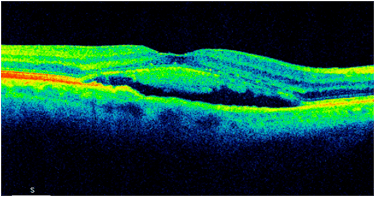
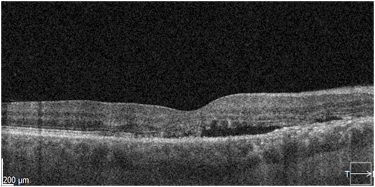
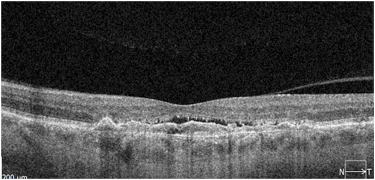

Centralna surowicza chorioretinopatia (CSCR)
aktualny stan wiedzy i opcje terapeutyczne
Epidemiologia
1. Schorzenie dotyka młodych ludzi, zwykle pomiędzy 20 i 50 rokiem życia. Średni wiek pacjenta z CSCR to czterdzieści kilka lat.
2. Schorzenie występuję częściej u mężczyzn niż u kobiet, ale przewaga mężczyzn w grupie chorych nie jest przytłaczająca, zwykle proporcja wynosi około 3 :1 (Spaide 1996, Tittle 1999).
Czynniki ryzyka
1. Ogólne:
a. Przyjmowanie leków sterydowych, przede wszystkim ogólnie, chociaż publikowane są pojedyncze doniesienia o występowaniu CSCR po miejscowym stosowaniu glikokortykoidów, n.p. po lekach wziewnych lub iniekcjach dostawowych. Haimovici et al. (2004) podają 37-krotny wzrost ryzyka wystąpienia CSCR u pacjentów poddawanych systemowej sterydoterapii w porównaniu z grupa kontrolną
b. Endogenna hiperkortyzolemia: CSCR występuje częściej u osób z zespołem Cushinga oraz w trzecim trymestrze ciąży (wzrost ryzyka wystąpienia CSCR siedmiokrotny – Haimovici et al. 2004)
c. Typ osobowości A, niedostosowanie społeczne
d. Przewlekły stres i/lub pojedyncze incydenty stresogenne, zmianowy system pracy, bezsenność
e. Inne, dyskutowane: Helicobacter pyroli w przewodzie pokarmowym, nadciśnienie tętnicze, alkoholizm, bezdech senny etc.
2. Miejscowe
a. Zwiększona grubość naczyniówki (pachychoroid)
b. Nadwzroczność ? Czynnik dyskutowany. CSCR występuje nierzadko również u osób z myopią.
Koncepcje patogenetyczne
1. Pachychoroid – zwiększenie kalibru dużych i średnich naczyń naczyniówki (warstwy Sattlera i Hallera) powoduje ucisk na choriokapilary, zwiększenie ich przepuszczalności i migrację surowiczego płynu poza ich światło. Wzrost ciśnienia hydrostatycznego w przestrzeni pozanaczyniowej powoduje uszkodzenie błony Brucha oraz rozszczelnienie zonula occludens RPE i migrację płynu pod siatkówkę sensoryczną (płyn podsiatkówkowy – SRF) i /lub surowicze odłączenie RPE (PED). Zmiany w RPE są w tej koncepcji wtórne do zaburzeń naczyniówki.
2. Dominujące zaburzenia naczyniówkowe lub współistnienie zaburzeń naczyniówki i RPE (Arrigo et al. 2021) już na etapie ostrej CSCR. W tej koncepcji nieprawidłowa funkcja RPE towarzyszy części postaci CSCR już na wczesnym etapie choroby, powodując poważniejsze uszkodzenie fotoreceptorów i siatkówki sensorycznej w porównaniu z postaciami „czystego” pachychoroidu.
3. Koncepcja ścieżki mineralokortykoidów. Hiperaktywacja receptorów dla mineralokortykoidów (MR) w różnych organach związana z zaburzeniami poziomów endogennych kortykoidów wywołuje zespół objawów systemowych i miejscowych składający się na obraz choroby. W naczyniówce aktywacja receptorów MR powoduje retencję wody oraz wzrost ciśnienia hydroststycznego w naczyniach, co prowadzi do typowych objawów pachychoroidu. Z kolei aktywacja receptorów MR w takich organach jak nerki, serce i mózg wywołuje nadciśnienie tętnicze, arytmię oraz zaburzenia psychologiczne, szczególnie nieprawidłową reakcję na stres. Konsekwencją przyjęcia tej koncepcji patogenetycznej CSCR jest stosowanie inhibitorów MR w terapii CSCR, przede wszystkim Eplerenonu.
Klasyfikacje CSCR
1. Tradycyjna, uzależniona od czasu trwania schorzenia.
a. Postaci ostre – czas trwania objawów do 4-6 miesięcy
b. Postaci przewlekłe – czas trwania powyżej 4-6 miesięcy.
2. Klasyfikacja oparta na diagnostyce multimodalnej (Chhablani et al. 2020). Podstawą klasyfikacji jest podział na postaci proste i skomplikowane uzależniony od powierzchni anomalii RPE widocznych w badaniu autofluorescencji (FAF). Punkt podziału 2 DA ( dwie powierzchnie tarczy nerwu wzrokowego). Tabela 1.
3. Klasyfikacja ostrej postaci CSCR (Arrigo et al. 2021)
a. Choroidal type – znacznie zwiększona grubość naczyniówki, powyżej 450 mm; brak istotnych zaburzeń na poziomie RPE
b. RPE – type – zaburzenia sygnału z RPE widoczne w SOCT
Postać naczyniówkowa rokuje lepiej co do zachowania widzenia i jest rzadziej powikłana wtórną CNV, w przeciwieństwie do RPE-type, która generalnie rokuje gorzej.
Diagnostyka CSCR
1. SOCT. Jest zwykle pierwszym badaniem wykonywanym u pacjenta z podejrzeniem CSCR. W postaciach prostych, ostrych najczęstszym objawem jest obecność hiporefleksyjnej przestrzeni płynowej pod siatkówką sensoryczną oraz wydłużenie fotoreceptorów. Dodatkowo obecne jest zwiększenie grubości siatkówki sensorycznej – obrzęk. Przy postaciach skomplikowanych mogą być obecne także ogniska PED. W miarę trwania CSCR wydłużenie fotoreceptorów zmniejsza się i zostaje zastąpione przez ziarnistości odpowiadające skupiskom makrofagów. W niektórych sytuacjach SRF może zawierać hiperrefleksyjne ogniska odpowiadające fibrynie (taki obraz jest charakterystyczny dla CSCR w trzecim trymestrze ciąży). Postaci długotrwałe CSCR zwykle wykazują bogactwo objawów widocznych w SOCT. Charakterystyczne jest ścieńczenie siatkówki sensorycznej, niekiedy cystowate zmiany w siatkówce sensorycznej, ubytki w RPE oraz ogniska PED.
2. Angio-OCT (OCTA). OCTA w CSCR jest czułym i skutecznym narzędziem do wykrywanie wtórnej neowaskularyzacji podsiatkówkowej. Błony CNV widoczne są na poziomie choriokapilar i niekiedy strefy awaskularnej i zwykle nie mają dużego rozmiaru (n.p. w porównaniu z MNV w NVAMD). Opis postaci CSCR powikłanej CNV znajduje się w dalszej części omówienia. OCTA pozwala również na ocenę obszarów pozbawionych sygnału z choriokapilar po przebytej CSCR. Z kolei w aktywnej postaci CSCR obraz wzmożonego sygnału z poziomu choriokapilar pozwala według niektórych autorów na planowanie terapii fotodynamicznej (PDT).
3. Autofluorescencja (FAF). Proste i nieinwazyjne narzędzie do oceny stanu RPE . Pozwala na widualizację charakterystycznych zmian typowych dla ostrych i przewlekłych postaci CSCR: hiperautofluorescencyjne skupiska lipofuscyny oraz zaniki RPE. W przypadku postaci długotrwałych FAF pokazuje tzw. „szlaki grawitacyjne” (gravitational tracks) , czyli geograficzne kształty odpowiadające obszarom obecności SRF (aktualnej lub przeszłej).
4. Angiografia fluoresceinowa (FA). Pozwala na lokalizację miejsca przecieku oraz kwalifikację typu CSCR do postaci prostej lub skomplikowanej. W przypadku postaci prostych zwykle mamy do czynienia z pojedynczym lub nielicznymi ogniskami przecieku, bez istotnych zaburzeń RPE. Postaci skomplikowane charakteryzują się licznymi ogniskami przecieku, czasami trudnymi do zidentyfikowania, obszarami PED oraz ubytkami w RPE. FA musi zostać wykonana w przypadku planowanej klasycznej fotokoagulacji laserowej miejsca przecieku.
5. Angiografia indocyjaninowa (ICGA). Umożliwia identyfikację obszarów wzmożonej przepuszczalności choriokapilar oraz stanowi najpewniejszą metodę diagnostyczną pozwalająca na planowanie PDT.
Kryteria rozpoznania CSCR
Nowoczesne kryteria rozpoznania CSCR zostały sformułowane przez CSCR International Group (Ophthalmology 2020).
Główne kryteria rozpoznania idiopatycznej postaci CSCR (oba konieczne)
• obecność SRF niezwiązanego z innymi jednostkami chorobowymi lub przyjmowaniem leków
• obecność przynajmniej 1 zaburzenia RPE w FAF
Drugorzędne kryteria rozpoznania idiopatycznej postaci CSCR (jedno konieczne)
• plackowata hiperfluorescencja w fazie pośredniej ICGA
• 1 lub więcej ognisk przecieku w FA
• grubość naczyniówki ≥ 400μm (uwaga na wiek i długość gałki ocznej
Przebieg CSCR
Większość przypadków CSCR ustępuje samoistnie w ciągu 1-3 miesięcy od wystąpienia objawów (ok 84%) (Daruich 2017). Pozostałe kilkanaście procent przechodzi w postaci przewlekłe, które stanowią problem diagnostyczny i terapeutyczny. Postaci krótkotrwałe zwykle nie powodują poważnego uszczerbku widzenia, ale większość pacjentów po przebytej CSCR skarży się na obniżenie jakości ostrości wzroku. Postaci przewlekle trwają nawet wiele lat i skutkują znaczącym upośledzeniem widzenia. Gawęcki et al. (2019) wykazali spadek BCVA o 4 linie na tablicach Snellena u pacjentów ze średnim czasem trwania objawów na poziomie 18 miesięcy. Z kolei Mrejen et al. (2019) podają 12.8% pacjentów z praktyczną ślepotą (BCVA 0.1 lub gorszą w obu oczach)po ok. 11 letniej obserwacji nie ustępującej postaci CSCR.
Znaczący odsetek CSCR jest powikłany wtórną neowaskularyzacją podsiatkówkową. Odsetek ten różni się znacząco w zależności od publikacji (2 – 40 %) i stosowanej metody diagnostycznej. Autorzy niniejszego omówienia szacują częstość występowania CNV w przebiegu CSCR na około 20 %. Co istotne, CNV w przebiegu CSCR dotyczy starszej grupy pacjentów (pod koniec szóstej dekady życia) oraz postaci długotrwałych. Dynamika CNV w CSCR jest zwykle mniejsza niż w przypadku NVAMD. Co ciekawe, wśród CNV obserwowanych w przebiegu CSCR jest grupa zmian, które trwają z obecnością SRF i brakiem pogorszenia ostrości wzroku pacjenta lub morfologiczną progresją samej błony
Opcje terapeutyczne w CSCR
1. Obserwacja. Obserwacja przez 3-4 miesiące w oczekiwaniu na spontaniczną remisję objawów była standardową forma postępowania w przypadkach pierwszych epizodów CSCR. Rekomendacja odraczania jakiejkolwiek procedury terapeutycznej została sformułowana w czasach, kiedy jedyna formą leczenia CSCR była klasyczna laserowa fotokoagulacja laserowa (LPC). Ta forma terapii powodowała powstawanie blizn i w konsekwencji mroczków w polu widzenia, stąd preferowana obserwacja przez kilka miesięcy. Współcześnie ta rekomendacja jest dyskutowana. Wiele badań pokazuje , że nawet krótkotrwałe epizody CSCR mogą doprowadzić do znacznych uszkodzeń w obrębie fotoreceptorów (Gawecki et al. 2020, 2023). W obliczu dostępności nieuszkadzających form laseroterapii, takich jak podprogowa laseroterapia mikropulsowa (SML), klinicyści często decydują się na interwencję terapeutyczną bez zwłoki. Również PDT jest niekiedy stosowana w postaciach ostrych na ich wczesnym etapie.
2. Fotokogulacja laserowa (LPC) miejsca przecieku. Przez kilka dekad LPC była podstawową forma leczenia CSCR. Warunkiem bezpiecznego zastosowania tej metody była i jest bezpieczna lokalizacja miejsca przecieku – w odpowiedniej odległości od centrum dołka. Dodatkowo, przeciek powinien być zlokalizowany, punktowy, a nie rozlany lub trudny do zidentyfikowania, jak to obserwujemy w niektórych przewlekłych postaciach CSCR. Zasady wykonywania LPC w CSCR sformułował Gass w latach 70-tych ubiegłego stulecia. Ze względu na uszkadzający charakter terapii zalecano najpierw obserwację przez kilka miesięcy. LPC stosowana była w przypadkach nieresorbującego się przecieku oraz w postaciach nawrotowych. Współcześnie LPC nadal jest stosowana, chociaż częściej terapię rozpoczyna się od laseroterapii podprogowej, n.p. SML. LPC jest dobrym rozwiązaniem w przypadku braku reakcji na SML. Jak wspomniano wcześniej, do wykonania LPC konieczne jest aktualne badanie angiograficzne (FA).
3. Podprogowa laseroterapia mikropulsowa (SML) . Jest nieuszkadzającą formą laseroterapii, która, jeżeli wykonana prawidłowo, nie powinna zostawiać w siatkówce żadnych śladów. Impuls lasera jest w niej podzielony na dużą liczbę krótkich impaktów, pomiędzy którymi następuje wychłodzenie tkanki. W efekcie, efektywny czas pracy lasera ustawiany jest na 5% (tzw. duty cycle). Badania pokazuję skuteczność tej formy laseroterapii, mierzonej jako całkowita resorpcja SRF, w CSCR na poziomie 40-80%, w zależności od publikacji. Wykonanie SML w CSCR polega na zlewnym pokryciu całego obszaru obrzęku siatkówki ogniskami lasera. Niekiedy stosuje się również panmakularną formę laseroterapii – stymulacji podlega wówczas siatkówka w całym biegunie tylnym. Użycie SML nie zapobiega występowaniu nawrotów tego schorzenia. SML nie zawsze jest skuteczny w skomplikowanych postaciach CSCR, zwłaszcza przy znacznym uszkodzeniu RPE. To logiczne, ponieważ założeniem SML jest stymulacja RPE, które stan warunkuje tez odpowiedź na laseroterapię. Trzeba tez podkreślić, że w długotrwałych postaciach CSCR efekt funkcjonalny SML jest zwykle ograniczony do poprawy BCVA na poziomie 1-2 linii na tablicach Snelelna.
4. Terapia fotodynamiczna (PDT). PDT jest metoda terapeutyczną stosowaną w leczeniu CSCR od 20 lat. Jej działanie polega na wywołaniu przejściowej okluzji choriokapilar i tym samym ograniczeniu ich przepuszczalności. W efekcie dochodzi do resorpcji SRF. Dodatkowo PDT wywołuje zmniejszenie grubości całej naczyniówki. Procedura polega na dożylny podaniu substancji fotouczulającej – verteporfiny. W leczeniu CSCT stosuje się strategię standardowej dawki : 6mg/m2 ciała lub połowy dawki: 3mg/m2 ciała (half dose – hd). Hd PDT jest współcześnie częściej stosowana. Niekiedy stosuje się również całą dawkę veretporfiny z połową fluencji lasera. Po ok. 15 minutach od jej podania wykonuje się naświetlanie obszaru wzmożonej przepuszczalności choriokapilar laserem o długości fali 689nm przez 83 sekundy (standardowa fluencja 50J/cm2). Obszar przecieku identyfikowany jest najpewniej za pomocą angiografii indocyjaninowej, ale możliwe jest także wykonanie terapii na podstawie wyników FA lub OCTA. Efekt laseroterapii obserwuje się zwykle po 2-4 tygodniach. Badania kliniczne pokazują, że PDT zapewnia najszybszy efekt leczniczy i najmniejszą liczbę nawrotów w CSCR. Jej skuteczność, mierzona odsetkiem pacjentów z całkowitą resorpcją SRF jest szacowana na 60-90 %. PDT jest zwykle stosowana w przewlekłych postaciach CSCR, ale jej skuteczność została także potwierdzona w przypadkach ostrych. Na PDT reagują dobrze przypadki ze zwiększoną grubością naczyniówki Główną wadą PDT jest jej wysoka cena i obecnie ograniczona dostępność. Podobnie jak w SML, poprawa funkcjonalna w postaciach przewlekłych CSCR jest dość niewielka.
5. Terapia anty-VEGF. Badania pokazują, że preparaty z grupy anty-VEGF dają efekt terapeutyczny w postaciach CSCR powikłanych neowaskularyzacją podsiatkówkową. Ich działanie w postaciach o charakterze tylko surowiczym jest znikome lub żadne. Trzeba też mieć świadomość, że błony MNV w CSCR niekiedy nie poddają się jakiejkolwiek terapii. Ich reakcja na anty -VEGF jest inna niż innych schorzeniach powikłanych rewaskularyzacją naczyniówkową np. AMD.
6. Eplerenon – inhibitor mineralokrtykoidów. Stosowanie Eplerenonu w CSCR jest odpowiedzią na teorię mineralokortykoidów. Zwykle stosuje się dawkę 25 – 50 mg dziennie przez 3-6 miesięcy. Zdania co do skuteczności tej terapii w CSCR sa podzielone. Duże metaanalizy wyników leczenia CSCR Eplerenonem nie potwierdzają jednoznacznie skuteczności tej metody. Wydaje się, że jest ona skuteczna u mniejszości pacjentów i wymaga jeszcze dalszych badaniach nad precyzyjnym scharakteryzowaniem grupy responderów.
7. Leki niesterydowe przeciwzapalne stosowane ogólnie lub miejscowo, leki moczopędne, inhibitory anhydrazy węglanowej. Brak danych potwierdzających skuteczność tych opcji terapeutycznych.
Strategie terapeutyczne.
Ważnym aspektem badań nad CSCR jest czas rozpoczęcia leczenia. Wiele badań nad tym schorzeniem pokazuje, że efekty leczenia postaci przewlekłych przynoszą mierną poprawę funkcjonalną. Wydaje się, że celem terapii powinno być niedopuszczenie do rozwoju postaci długotrwałej i skomplikowanej, czyli rozpoczęcie terapii wcześnie. Okres kilkumiesięcznej obserwacji w oczekiwaniu na spontaniczną remisję, zalecany kilka dekad temu, może doprowadzić do nieodwracalnych uszkodzeń w siatkówce sensorycznej, trwałego spadku ostrości wzroku i co jest z tym związane jakości życia pacjenta. Niemniej, solidny konsensus co do rekomendacji terapeutycznych w CSCR nie został na razie osiągnięty. Autorzy tego omówienia preferują rozpoczęcie leczenia wcześnie, wkrótce po wystąpieniu pierwszych objawów. Leczenie można rozpocząć od SML, zarówno w opcji 577 jak i 810 nm, jednak w razie braku reakcji na laseroterapię oraz przy widocznych już ubytkach fotoreceptorów, należy niezwłocznie wykonywać PDT. Przy braku dostępności tej metody warto też rozważyć powtórzenie FA i wykonanie klasycznej LPC. Trzeba podkreślić, że pomimo stosowania tych wszystkich opcji terapeutycznych, w postaciach długotrwałych CSCR rzadko odnotowuje się znaczącą poprawę funkcjonalną.
Podsumowanie
CSCR jest powszechną, ale nie w pełni poznaną i zrozumianą chorobą.
Obecne teorie jej patogenezy podkreślają przeciążenie krążenia naczyniówkowo-żylnego, prawdopodobnie z powodu zmniejszonego odpływu żył wirowatych przez pogrubioną twardówkę.
Klasyfikacja na podtypy ostre lub przewlekłe może pomóc w określeniu potrzeby interwencji, ale ma ograniczenia, które częściowo rozwiązują nowsze schematy klasyfikacji.
Obrazowanie multimodalne jest konieczne do postawienia prawidłowej diagnozy i zaplanowania terapii.
Modyfikacja czynników ryzyka, w szczególności zaprzestanie stosowania kortykosteroidów, powinna być podkreślana u wszystkich pacjentów.
PDT ma najsilniejsze dowody na leczenie nie ustępującego SRF wtórnego do CSC, ale fotokoagulacja laserem argonowym i laser mikropulsowy mogą odgrywać rolę w niektórych sytuacjach.
OCT-A jest preferowane do wykrywania CSC połączonych z CNV, które reagują na doszklistkową terapię anty-VEGF.
Sztuczna inteligencja (AI) może stać się przydatnym narzędziem w prognozowaniu i kierowaniu leczeniem CSC w przyszłości.
Bibliografia
Spaide RF, Campeas L, Haas A, Yannuzzi LA, Fisher YL, Guyer DR, Slakter JS, Sorenson JA, Orlock DA. Central serous chorioretinopathy in younger and older adults. Ophthalmology. 1996 Dec;103(12):2070-9
Tittl MK, Spaide RF, Wong D, Pilotto E, Yannuzzi LA, Fisher YL, Freund B, Guyer DR, Slakter JS, Sorenson JA. Systemic findings associated with central serous chorioretinopathy. Am J Ophthalmol. 1999 Jul;128(1):63-8
Haimovici R, Koh S, Gagnon DR, Lehrfeld T, Wellik S; Central Serous Chorioretinopathy Case-Control Study Group. Risk factors for central serous chorioretinopathy: a case-control study. Ophthalmology. 2004 Feb;111(2):244-9.
Garg SP, Dada T, Talwar D, Biswas NR. Endogenous cortisol profile in patients with central serous chorioretinopathy. Br J Ophthalmol. 1997 Nov;81(11):962-4.
Haimovici R, Rumelt S, Melby J. Endocrine abnormalities in patients with central serous chorioretinopathy. Ophthalmology. 2003 Apr;110(4):698-703. doi: 10.1016/S0161-6420(02)01975-9. PMID: 12689888.
Karska-Basta, I.; Pociej-Marciak, W.; Chrząszcz, M.; Kubicka-Trząska, A.; Dębicka-Kumela, M.; Gawęcki, M.; Romanowska-Dixon, B.; Sanak, M. Imbalance in the levels of angiogenic factors in patients with acute and chronic central serous chorioretinopathy. J. Clin. Med. 2021, 10, 1087.
Karska-Basta, I.; Pociej-Marciak, W.; Chrząszcz, M.; Kubicka-Trząska, A.; Romanowska-Dixon, B.; Sanak, M. Altered plasma cytokine levels in acute and chronic central serous chorioretinopathy. Acta Ophthalmol. 2021, 99, e222–e231.
Castro-Navarro V, Behar-Cohen F, Chang W, Joussen AM, Lai TYY, Navarro R, Pearce I, Yanagi Y, Okada AA. Pachychoroid: current concepts on clinical features and pathogenesis. Graefes Arch Clin Exp Ophthalmol. 2021 Jun;259(6):1385-1400.
Arrigo A, Aragona E, Bordato A, Calamuneri A, Moretti AG, Mercuri S, Bandello F, Parodi MB. Acute Central Serous Chorioretinopathy Subtypes as Assessed by Multimodal Imaging. Transl Vis Sci Technol. 2021 Nov 1;10(13):6.
Daruich A, Matet A, Dirani A, Bousquet E, Zhao M, Farman N, Jaisser F, Behar-Cohen F. Central serous chorioretinopathy: Recent findings and new physiopathology hypothesis. Prog Retin Eye Res. 2015 Sep;48:82-118.
Multimodal Imaging-Based Central Serous Chorioretinopathy Classification Jay Chhablani, MD1 - Pittsburgh, Pennsylvania Francine Behar Cohen, MD, PhD2 - Paris, France On behalf of the Central Serous Chorioretinopathy International Group Ophthalmology 2020
Gawecki M, Groszewska E. Central serous chorioretinopathy during pregnancy complicated by systemic hypertension - a case report. Klin Oczna. 2016 Sep;117(4):256-259.
Spaide RF, Hall L, Haas A, Campeas L, Yannuzzi LA, Fisher YL, Guyer DR, Slakter JS, Sorenson JA, Orlock DA. Indocyanine green videoangiography of older patients with central serous chorioretinopathy. Retina. 1996;16(3):203-13.
Hua R, Yao K, Xia F, Li J, Guo L, Yang G, Tao J. The hyper-fluorescent transitional bands in ultra-late phase of indocyanine green angiography in chronic central serous chorioretinopathy. Lasers Surg Med. 2016 Mar;48(3):260-3. doi: 10.1002/lsm.22434. Epub 2015 Oct 19. PMID: 26482206.
Gawęcki M, Jaszczuk-Maciejewska A, Jurska-Jaśko A, Kneba M, Grzybowski A. Impairment of visual acuity and retinal morphology following resolved chronic central serous chorioretinopathy. BMC Ophthalmol. 2019 Jul 25;19(1):160.
Mrejen S, Balaratnasingam C, Kaden TR, Bottini A, Dansingani K, Bhavsar KV, Yannuzzi NA, Patel S, Chen KC, Yu S, Stoffels G, Spaide RF, Freund KB, Yannuzzi LA. Long-term Visual Outcomes and Causes of Vision Loss in Chronic Central Serous Chorioretinopathy. Ophthalmology. 2019 Apr;126(4):576-588. doi: 10.1016/j.ophtha.2018.12.048. Epub 2019 Jan 17. PMID: 30659849.
Sacconi R, Tomasso L, Corbelli E, Carnevali A, Querques L, Casati S, Bandello F, Querques G. Early response to the treatment of choroidal neovascularization complicating central serous chorioretinopathy: a OCT-angiography study. Eye (Lond). 2019 Nov;33(11):1809-1817. doi: 10.1038/s41433-019-0511-2. Epub 2019 Jul 2. PMID: 31267094; PMCID: PMC7002717.
Matet A, Daruich A, Hardy S, Behar-Cohen F. PATTERNS OF CHORIOCAPILLARIS FLOW SIGNAL VOIDS IN CENTRAL SEROUS CHORIORETINOPATHY: An Optical Coherence Tomography Angiography Study. Retina. 2019 Nov;39(11):2178-2188. doi: 10.1097/IAE.0000000000002271. PMID: 30028410.
Daruich A, Matet A, Marchionno L, De Azevedo JD, Ambresin A, Mantel I, Behar-Cohen F. ACUTE CENTRAL SEROUS CHORIORETINOPATHY: Factors Influencing Episode Duration. Retina. 2017 Oct;37(10):1905-1915.
Chhablani J, Kozak I, Pichi F, Chenworth M, Berrocal MH, Bedi R, Singh RP, Wu L, Meyerle C, Casella AM, Mansour A, Bashshur Z, Scorza A, Carrai P, Nucci P, Arevalo JF; King Khaled Eye Specialist Hospital International Collaborative Retina Study Group. OUTCOMES OF TREATMENT OF CHOROIDAL NEOVASCULARIZATION ASSOCIATED WITH CENTRAL SEROUS CHORIORETINOPATHY WITH INTRAVITREAL ANTIANGIOGENIC AGENTS. Retina. 2015 Dec;35(12):2489-97.
Gawęcki M, Grzybowski A, Pompein-Batkiewicz M. Significant Visual Impairment after Short-Lasting Central Serous Chorioretinopathy. Case Rep Ophthalmol. 2022 Sep 19;13(3):678-685. doi: 10.1159/000525924. PMID: 36742018; PMCID: PMC9896455.
Gawęcki M, Jaszczuk A, Grzybowski A. Short Term Presence of Subretinal Fluid in Central Serous Chorioretinopathy Affects Retinal Thickness and Function. J Clin Med. 2020 Oct 26;9(11):3429. doi: 10.3390/jcm9113429. PMID: 33114519; PMCID: PMC7692782.
Gass J.D.M.(1974a).Discussion of central serous retinopathy. Modern Problems in Ophthalmology, 12, 361. Karger: Basel.
Gawęcki M, Jaszczuk-Maciejewska A, Jurska-Jaśko A, Grzybowski A. Functional and morphological outcome in patients with chronic central serous chorioretinopathy treated by subthreshold micropulse laser. Graefes Arch Clin Exp Ophthalmol. 2017 Dec;255(12):2299-2306. doi: 10.1007/s00417-017-3783-x. Epub 2017 Aug 22. PMID: 28831603; PMCID: PMC5696495.
Vignesh TP, Maitray A, Sen S, Chakrabarti A, Kannan NB, Ramasamy K. Subthreshold Micro-Pulse Yellow Laser and Eplerenone Drug Therapy in Chronic Central Serous Chorio-Retinopathy Patients: A Comparative Study. Semin Ophthalmol. 2020 May 18;35(4):237-245. doi: 10.1080/08820538.2020.1809682. Epub 2020 Aug 27. PMID: 32853034.
Işık MU, Değirmenci MFK, Sağlık A. Efficacy of the subthreshold micropulse yellow wavelength laser photostimulation in the treatment of chronic central serous chorioretinopathy. Int J Ophthalmol. 2020 Sep 18;13(9):1404-1410. doi: 10.18240/ijo.2020.09.11. PMID: 32953579; PMCID: PMC7459231.
Efficacy and safety of subthreshold micropulse laser in the treatment of acute central serous chorioretinopathy. Int J Ophthalmol. 2023 Jun 18;16(6):921-927
Kiraly P, Habjan MŠ, Smrekar J, Mekjavić PJ. Functional Outcomes and Safety Profile of Trans-Foveal Subthreshold Micropulse Laser in Persistent Central Serous Chorioretinopathy. Life (Basel). 2023 May 16;13(5):1194. doi: 10.3390/life13051194. PMID: 37240839; PMCID: PMC10223243.
Kim YJ, Kim SY, Ha S, Moon D, Seong S, Kwon OW, Park HS. Short-duration multiple-session subthreshold micropulse yellow laser (577 nm) for chronic central serous chorioretinopathy: results at 3 years. Eye (Lond). 2019 May;33(5):819-825. doi: 10.1038/s41433-018-0309-7. Epub 2019 Jan 4. PMID: 30610228; PMCID: PMC6707150.
Iacono P, Da Pozzo S, Varano M, Parravano M. Photodynamic Therapy with Verteporfin for Chronic Central Serous Chorioretinopathy: A Review of Data and Efficacy. Pharmaceuticals (Basel). 2020 Oct 29;13(11):349
Katz G, Gur E, Moisseiev J, Leshno A. Early versus delayed photodynamic therapy for chronic central serous chorioretinopathy. Int Ophthalmol. 2023 Nov;43(11):4055-4065. doi: 10.1007/s10792-023-02822-y. Epub 2023 Jul 27. PMID: 37498446.
Kamimura A, Miki A, Kishi M, Okuda M, Hayashida-Hirano M, Sakamoto M, Matsumiya W, Imai H, Kusuhara S, Nakamura M. Two-year outcome of half-time photodynamic therapy for chronic central serous chorioretinopathy with and without choroidal neovascularization. PLoS One. 2023 May 2;18(5):e0284979. doi: 10.1371/journal.pone.0284979. PMID: 37130134; PMCID: PMC10153719.
Khandhadia S, Thulasidharan S, Hoang N, Ibrahim S, Ouyang Y, Lotery A. Real world outcomes of photodynamic therapy for chronic central serous chorioretinopathy. Eye (Lond). 2023 Aug;37(12):2548-2553. doi: 10.1038/s41433-022-02370-2. Epub 2022 Dec 26. PMID: 36572748; PMCID: PMC10397181.
van Rijssen T, van Dijk E, Tsonaka R, Feenstra H, Dijkman G, Peters P, Diederen R, Hoyng C, Schlingemann R, Boon C. Half-Dose Photodynamic Therapy Versus Eplerenone in Chronic Central Serous Chorioretinopathy (SPECTRA): A Randomized Controlled Trial. Am J Ophthalmol. 2022 Jan;233:101-110. doi: 10.1016/j.ajo.2021.06.020. Epub 2021 Jun 29. PMID: 34214454.
Liu J, Chen C, Li L, Xu Y, Yi Z, He L, Zheng H. Assessment of choriocapillary blood flow changes in response to half-dose photodynamic therapy in chronic central serous chorioretinopathy using optical coherence tomography angiography. BMC Ophthalmol. 2020 Oct 7;20(1):402. doi: 10.1186/s12886-020-01674-9. Erratum in: BMC Ophthalmol. 2020 Nov 12;20(1):445. PMID: 33028272; PMCID: PMC7542766.
Felipe CQ, Biancardi AL, Civile VT, Carvas Junior N, Serracarbassa PD, Koike MK. Mineralocorticoid receptor antagonists for chronic central serous chorioretinopathy: systematic review and meta-analyses. Int J Retina Vitreous. 2022 Jun 7;8(1):34. doi: 10.1186/s40942-022-00385-1. PMID: 35672807; PMCID: PMC9172176.
Wang SK, Sun P, Tandias RM, Seto BK, Arroyo JG. Mineralocorticoid Receptor Antagonists in Central Serous Chorioretinopathy: A Meta-Analysis of Randomized Controlled Trials. Ophthalmol Retina. 2019 Feb;3(2):154-160. doi: 10.1016/j.oret.2018.09.003. Epub 2018 Sep 15. PMID: 31014765.
Karska-Basta, I.; Pociej-Marciak, W.; Chrząszcz, M.; Żuber-Łaskawiec, K.; Sanak, M.; Romanowska-Dixon, B. Quality of life of patients with central serous chorioretinopathy—A major cause of vision threat among middle-aged individuals. Arch. Med. Sci. 2021, 17, 724–730.

Obraz SOCT w różnych postaciach CSCR. Postać ostra charakteryzuje się wydłużeniem fotoreceptorów oraz brakiem ścieńczenia siatkówki sensorycznej. Z kolei postaci przewlekłe mogą przybierać różne formy morfologiczne: na jednym zdjęciu widoczna jest hiperrefleksyjna fibryna w płynie siatkówkowym oraz ziarnistości na granicy siatkówki sensorycznej. Z kolei drugi przykład pokazuje znaczne ubytki siatkówki sensorycznej pomimo resorpcji SRF po wykonanej SML.
Zdjęcia angiografii fluoresceinowej oraz indocyjaninowej w ostrej i przewlekłej postaci CSCR. W dwóch przypadkach ostrych przeciek w FA przyjmuje formę kleksa lub snopu dymu. W postaci przewlekłej ogniska przecieku są trudne do zlokalizowania, bardziej widoczny jest „staining” siatkówki. W badaniu ICGA widoczna jest wzmożona przepuszczalność choriokapilar w fazie pośredniej angiogramu.

Trzy przykłady CSCR powikłanej MNV. Na skanach SOCT widoczne wyraźne uniesienie RPE z hiperrefleksyjną struktura pod RPE. Badanie OCTA ujawnia sieć naczyniową błony. Trzeci przykład pokazuje długotrwałą MNV po leczeniu anty VEGF – zwraca uwagę rzadka sieć naczyniowa błony.




Stan po klasycznej fotokoagulacji laserowej siatkówki. Pacjent po wielokrotnej laseroterapii mikropulsowej – bez resorpcji płynu podsiatkówkowego. Wykonano ponownie FA i wykonano ogniskową laseroterapie na podstawie wyniku badania (zaznaczony okrąg). W SOCT widoczna całkowita resorpcja plynu, ale również znaczne ścieńczenie siatkówki.










Trzy przykłady SML z dobrym efektem terapeutycznym wykonanej w długotrwałej postaci CSCR.




Przykłady PDT wykonanej z sukcesem u dwóch pacjentów ze zwiększona grubością naczyniówki.
Dwa przykłady nieskutecznej terapii fotodynamicznej w przebiegu CSCR. Zwraca uwagę brak pogrubienia naczyniówki u tych pacjentów.


